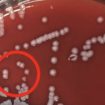

ესპანეთში მიტოვებული მატარებლის სადგური ხუთვარსკვლავიან სასტუმროდ გადააკეთეს. არაგონის ველზე კანფრანკის სადგური პირველად 1928 წელს გაიხსნა. გრანდიოზული საერთაშორისო სადგური გახსნას ესპანეთის
ახალი კვლევა აჩენს იმის ვარაუდის საფუძველს, რომ შესაძლოა, მხოლოდ ერთი ინექციით შესაძლებელი გახდეს სიმთვრალის ან ალკოჰოლით მოწამვლის ეფექტის სწრაფი შემსუბუქება. თაგვებზე ჩატარებულმა კვლევამ აჩვენა, რომ ამის მიღწევა ჰორმონ ფიბრობლასტის ზრდის